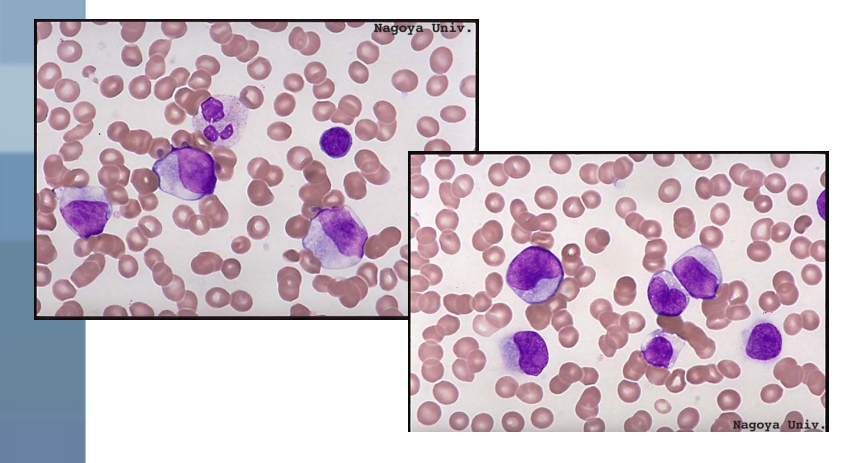
<p>what are the lab findings for AML?</p>

1/171
unfinished
Name | Mastery | Learn | Test | Matching | Spaced | Call with Kai |
|---|
No analytics yet
Send a link to your students to track their progress
what are leukemias?
malignant disease of blood and blood forming organs that is characterized by uncontrolled proliferation and accumulation of leukocytes in the PB → identified as to the cell type involved (lymphocytic, myelogenous (granulocytic), monocytic)
how are leukemias classified?
based on:
morphology
cytochemistry
cytogenetics
surface markers
molecular probes
what are the distinct characteristics of acute leukemia that will differentiate it from chronic leukemia?
bone marrow and peripheral blood contain abnormal numbers of immature WBCs (blasts)
clinical course if untreated is short (usually months)
what are the distinct characteristics of chronic leukemia that will differentiate it from acute leukemia?
large number of WBCs are more mature than blasts found in bone marrow
longer clinical course (years)
what is the etiology of leukemias?
some are idiopathic
viruses
genetic predisposition
chromosomal abnormalities
drugs, chemicals
benzene, chloramphenicol, chemo
irradiation
immunologic deficiencies
what is the virus that can cause a type of leukemia?
human T-cell leukemia/lymphoma virus-1 (HTLV-1) → implicated as the cause for adult T-cell leukemia/lymphoma
how can genetic predisposition cause leukemia?
identical twin of a patient with acute leukemia has a greater risk of developing leukemia
how can chromosomal abnormalities cause leukemia?
in patients with down syndrome and other disorders associated with abnormal chromosome number or chromosome fragility have been known to have an increased frequency of leukemia
how are survivors of hiroshima prone to leukemia?
has 100x the incidence of leukemia compared to the general population → irradiation damaged chromosomes which may have resulted in abnormalities in offspring, causing the development of neoplasms
what is the cellular kinetics in acute leukemia?
blasts do not really proliferate rapidly but accumulates → has a longer or a normal cell cycle time but doesn’t mature (maturation arrest)
what is the cellular kinetics in early acute leukemic conditions?
hyperproliferation occurs; however, when the leukemic cell load becomes excessive, many of the cells become nonproliferative (accumulates instead)
what are the cellular kinetics in chronic lymphocytic leukemia (CLL)?
accumulation of large numbers of long lived slowly dividing cells that are functional abnormal
what are the cellular kinetics in chronic myelocytic leukemia (CLL)?
hyperproliferation of myeloid precursors → cell cycle times are normal but there is a greater number of cells undergoing proliferation at the same time meaning the cells are longer-lived than normal
where do leukemic cells (acute and chronic) recirculate?
between the BM, PB, and other organs like the spleen, liver, and may also infiltrate the skin
what are the two major categories in acute leukemias?
lymphoblastic (ALL) and nonlymphoblastic (ANLL)
subtypes can be ID based on morphological, cytochemical, immunologic, and cytogenetic criteria of the malignant cells
what would the peripheral blood look like in acute leukemias relating to the WBCs?
blasts usually compose from 15-95% of all leukocytes and traditionally will have elevated WBC counts but up to 50% may be normal or decreased
blasts with azurophilic granules (primary) can be helpful in IDing the myeloid nature of the leukemia
>20% of the PB has to be blasts
gap in the normal maturation pyramid of cells → many blasts and some mature forms but very few intermediate stages (leukemia hiatus)
auer rods (fused granules) are only found in myelocytic cells
myeloblasts, monoblasts, and occasionally the more differentiated forms of these cells
excludes a diagnosis of ALL
what would the peripheral blood look like in acute leukemias relating to the RBCs?
RBC population is usually suppressed and HB values of less than 10 g/dL are common
RBCs could be slightly macrocytic (>100 fL) due to an inability to successfully compete with neoplastic cells for folate or vitamin B12
folate/vitamin b12 is essential for RBC production
RDW may be elevated
Howell Jolly bodies, pappenheimer bodies, and basophilic stippling may be present
NRBC may be present in proportion to the anemia or marrow damage
what would the peripheral blood look like in acute leukemias relating to the platelets?
platelets are typically decreased
occasional enlarged forms could be present (giant platelets)
may see more immature platelet forms like megakaryocytic fragments
what is ANLL and how is it classified?
acute non-lymphocytic leukemia and classified into 7 main groups that are collectively called the acute myeloid leukemias or acute myeloblastic leukemias (AML) using the FAB classification
what is FAB AML M0?
acute myeloblastic leukemia without differentiation → myeloblasts without granules
what is FAB AML M1?
acute myeloblastic leukemia with minimal differentiation → myeloblasts with or without scant granules
what is FAB AML M2?
acute myeloblastic leukemia with maturation → leukemia cells how prominent maturation beyond myeloblast stage
what is FAB APL M3?
promyelocytic leukemia → abnormal, hypergranular promyelocytes dominate; auer rods easily found; increased incidence of DIC
what is FAB APL M3m?
microgranular variant of M3 leukemia → indistinct granules; nucleus is often reniform or bilobed; increased incidence of DIC
what is FAB AML M4?
acute myelomonocytic leukemia → has both monocytic (monocytes and promonocytes) myeloid differentiation (maturation beyond myeloblast stage)
what is FAB AML M4Eo?
acute M4 leukemia with bone marrow eosinophilia → similar to M4 with marrow eosinophilia (abnormal and immature); associated with abnormal 16q karyocyte
what is FAB AML M5a?
acute monocytic leukemia that is poorly differentiated → monoblasts predominate, typically with abundant cytoplasm and single distinct nucleoli
what is FAB AML M5b?
acute monocytic leukemia that is well differentiated → predominantly promonocytes in marrow and more pronounced maturation in blood
what is FAB AML M6?
acute erythroleukemia → dysplastic erythroblasts with multinucleation, cytoplasmic budding, vacuolation, and megaloblastoid changes
what is FAB AML M7?
megakaryocytic leukemia → wide range of morphology, cytoplasmic projections sometimes present; electron microscopy or immunocytochemical stains necessary for diagnosis
what is acute myelocytic, myelogenous, or myeloblastic leukemia (AML)?
designated M0, M1, and M2 in FAB classification that accounts for over 50% of AML cases → common in ages 15-39 years with males being more susceptible (2:1)
what are the clinical presentations for AML?
infections
fever
bleeding (petechiae or purpura)
pallor (due to anemia)
minimal enlargement of spleen and liver (hepatosplenomegaly)
bone tenderness
what are the lab findings for AML?
WBC count is increased → 15.0 - 50.0 × 10³/uL with numerous blasts (PB >20%)
auer body or auer rods are present
bone marrow blasts are >30% of the population
iron staining may show ringed sideroblasts
presence of basket or smudge cells (bare nucleus)
blasts are usually positive when stained with cytoplasmic myeloperoxidase and sudan black
bone marrow transplant is usually the only option
what are auer body/rods in AML?
needle-like structure in cytoplasm representing coalesced azurophilic primary granules that are found in ~40% of AML cases
indicates that these blasts are myeloblasts or monoblasts, but not lymphoblasts or erythroblasts
what is acute promyelocytic leukemia (APL; M3)?
the one AML in which female patients outnumber males and is typically seen in young adults and the elderly → sudden and severe progression and acute DIC
what are the characteristics of acute promyelocytic leukemia (APL; M3)?
large number of promyelocytes, with numerous cytoplasmic granules in the BM and PB where auer rods are commonly found
cytogenetic analysis shows consistent chromosomal abnormality of a translocation from chromosome 15 to chromosome 17
what are key diagnostic issues in acute promyelocytic leukemia (APL; M3)?
promyelocytes tend to be hypogranular and mistaken for monocytes → need to use cytochemistry and cytogenetics to ID
what is acute myelomonocytic leukemia (AMML; M4)?
most common leukemia of the elderly → 20-30% of all AML cases with males being more susceptible
what are the peripheral blood characteristics in acute myelomonocytic leukemia (AMML; M4)?
WBCs are usually increased with the potential appearance of auer rods (any cell that have granules will have these)
greater than 30% of cells in BM are blasts with characteristics of both myeloblasts and monoblasts
blasts will vary in number and type
some blasts are impossible to distinguish as myelocytic or monocytic because they have cytochemical rxns of both cell lines
anemia and thrombocytopenia
increase in monocytic cells (monoblasts, promonocytes, monocytes)
nonspecific esterase staining identifies monoblasts
what is a lab finding that is associated with acute myelomonocytic leukemia (AMML; M4)?
increased levels of lysozyme (found in neutrophils and monocytes) in blood and urine of M4 patients that is 3x normal
what is acute monocytic leukemia (M5a, M5b)?
accounts for 5-15% of AML causes and is usually seen in children or young adults
what are the clinical findings in acute monocytic leukemia (M5a, M5b)?
weakness
bleeding (bleeding gums)
skin, gum, CNS, lymph node and extramedullary infiltrates are common
DIC is common
what are the bone characteristics in acute monocytic leukemia (M5a, M5b)?
80% of more of all non-erythroid cells are monocytic
what are the specific characteristics of acute monocytic leukemia M5a?
monoblasts account for >= 80% of monocytes in bone marrow and some monoblasts may be found in the PB
what are the specific characteristics of acute monocytic leukemia M5b?
monoblasts are <80% of monocytes in bone marrow and monocytes in PB are increases (monoblasts are often present)
what is erythroleukemia (M6) or DiGuglielmo’s syndrome?
rare form of leukemia (<5% of AML cases) that is almost nonexistent in children that primarily affects the erythroid cells → bleeding (and bruising) is a clinical manifestation
what are the peripheral blood characteristics in erythroleukemia (M6) or DiGuglielmo’s syndrome?
anemia with marked aniso and poik
NRBCs are present
>= 5 NRBCs need to be corrected
LAP is normal and increased
LAP looks at the number of younger cells
WBC and platelets are usually decreased
blasts may be found
what is the hallmark feature of erythroleukemia (M6) or DiGuglielmo’s syndrome?
greater than 50% of cells in BM are NRBCs that show severe dyserythropoiesis (multinucleated, megaloblastoid)… RBC precursors are abnormal too
WBC blasts comprise greater than 30% of all nucleated cells in the BM
what stain is positive in erythroleukemia (M6) or DiGuglielmo’s syndrome and what is the limitation?
abnormal RBC precursors are PAS (periodic acid Schiff) positive but PAS can be seen with other severe anemias and therefore not specific for M6 leukemia
what is megakaryoblastic leukemia (M7)?
rare disease that will not have normal functioning platelets that leads to anemias (result of the symptoms) → pallor and weakness due to anemia and bleeding with no organomegaly (no enlarged organS0
what would the PB look like in megakaryoblastic leukemia (M7)?
pancytopenia followed by a high blast count in later stages of the disease
micromegakaryocytes and undifferentiated blasts could be found
megakaryoblasts will proliferate
megakaryocyte fragments and giant platelets could be present
proliferates
atypical megakaryocytes will be in BM and will proliferate
what is necessary for the diagnosis of megakaryoblastic leukemia (M7)?
electron microscopy studies for platelet peroxidase or immunological studies for platelet specific antigens
what is done when more than 10 smudge cells are seen in a smear?
25% bovine albumin is added → 1 drop bovine and 5 drops patient sample
what are the cytochemical reactions of FAB AML M0?
MPO
neg
specific
neg
nonspecific
neg
what are the cytochemical reactions of FAB AML M1?
MPO
pos
specific
pos
nonspecific
neg
what are the cytochemical reactions of FAB AML M2?
MPO
pos
specific
pos
nonspecific
neg
what are the cytochemical reactions of FAB AML M3?
MPO
pos
specific
pos
nonspecific
neg
what are the cytochemical reactions of FAB AML M4?
MPO
pos
specific
pos
nonspecific
pos
what are the cytochemical reactions of FAB AML M5a?
MPO
neg
specific
neg
nonspecific
pos
what are the cytochemical reactions of FAB AML M5b?
MPO
neg
specific
neg
nonspecific
pos
what are the cytochemical reactions of FAB AML M6?
MPO
pos
specific
neg
nonspecific
var
what are the cytochemical reactions of FAB AML M7?
MPO
neg
specific
neg
nonspecific
pos
what is acute lymphocytic leukemia (ALL)?
heterogenous group of leukemias with three subtypes: L1, L2, and L3
what is L1 of acute lymphocytic leukemia (ALL)?
common childhood type
peak incidence between the ages of 2-5 years
with treatment, most children appear to be “cured”
without treatment, short survival
what is L2 of acute lymphocytic leukemia (ALL)?
common in adults
onset of symptoms is shorter
not as easily treated as L1
lesser quality of remission
what is L3 of acute lymphocytic leukemia (ALL)?
B-ALL → leukemic phase of Burkitt’s lymphoma which is the rarest and most aggressive form of ALL
what are the clinical presentations of acute lymphocytic leukemia?
easy fatigue (anemia)
infections (fever)
WBCs are nonfunctional
bleeding
enlarged lymph nodes and spleen
has a propensity for the CNS system (stiff necks, headaches)
moderate to severe anemia (normocytic, normochromic)
what are the lab findings of acute lymphocytic leukemia?
about ½ of patients have normal WBCS while the remainder has WBCs up to 100 × 10³/uL and platelet counts are usually decreased (5 × 10³/uL)
bone marrow is hypercellular with infiltration of lymphoblasts
what would be seen in the differential for acute lymphocytic leukemia?
nearly 100% of cells are lymphoid, mostly lymphoblasts with a mixture of immature and mature lymphocytes
many basket and smudge cells are formed by the pressure exerted in preparation of wedge smears on fragile abnormal cells
what is the cell size in FAB ALL L1?
predominantly small cells, homogenous
what is the cell size in FAB ALL L2?
large but heterogenous
what is the cell size in FAB ALL L3?
large but homogenous
what are the nuclear chromatin characteristics in FAB ALL L1?
homogenous with a single case (pt)
what are the nuclear chromatin characteristics in FAB ALL L2?
heterogenous
what are the nuclear chromatin characteristics in FAB ALL L3?
finely stippled and homogenous
what are the nuclear shape characteristics in FAB ALL L1?
regular with occasional clefting (indentation/split in the nucleus)
what are the nuclear chromatin characteristics in FAB ALL L2?
irregular, clefting, and indentation common
what are the nuclear chromatin characteristics in FAB ALL L3?
regular (round to oval)
what are the nucleoli cytoplasm characteristics in FAB ALL L1?
inconspicuous and scanty
what are the nucleoli cytoplasm characteristics in FAB ALL L2?
one or more; often large… variable; often moderately abundant
what are the nucleoli cytoplasm characteristics in FAB ALL L3?
one or more and is often prominent; moderately abundant, strongly basophilic
what is the cytoplasmic vacuolization characteristics in FAB ALL L1 and L2?
variable
what is the cytoplasmic vacuolization characteristics in FAB ALL L3?
prominent
how is immunophenotyping of ALL essential?
can identify the immunological subtype (is it a T or a B cell?) of the neoplastic lymphocyte by using surface markers and intracellular markers → this info has important prognostic implications and can distinguish lymphoid form myeloid neoplasms, define mixed cell lineages and identify minimal residual disease
what is the therapy regarding acute lymphocytic leukemia?
chemotherapy, radiotherapy, antibiotics, bone marrow and stem cell transplants (for patients who are “cured” by wiping out old HSC’s and new HSC’s are added)
treatment protocols and prognosis are proving to be more effective and accurate when the leukemic cell is immunologically classified
therapy response can be monitored using immunophenotyping
what are the characteristics of chronic myelocytic leukemia (CML)?
neoplastic growth of primary myeloid cells in the BM with an extreme elevation of these cells in the PB
has 3 phases to the disease
initial chronic phase
accelerated phase
blastic leukemia (blast crisis)
goal of treatment is to keep them out of this
what is a hallmark feature of chronic myelocytic leukemia (CML)?
philadephia chromosome which is an acquired chromosome that is consistent associated with CML → translocation of chromosomes 9 & 22
what is an important differentiation for CML?
needs to be differentiated from a leukemoid reaction → leukemoid reaction is caused by bacterial infections, and other myeloproliferative disorders like polycythemia vera
what are the key features in chronic myelogenous leukemia (CML) or chronic granulocytic leukemia (CGL)?
common in 40-60 years and has almost equal distribution among sexes
patient is relatively asymptomatic with prominent spleen and lymph nodes are rarely enlarged
all stages of cellular development are found in BM and PB
quantitative and/or qualitative platelet abnormalities (petechiae)
anemia
what are the key lab findings in chronic myelogenous leukemia (CML) or chronic granulocytic leukemia (CGL)?
elevated WBC count
50.0 - 200.0 × 10³/uL → counts can be as high as 1000.0 × 10³/uL
differential is a bimodal distribution of myelocytes and neutrophils and both exceed in number over the other cell types
basophilia
neutrophils show decreased LAP activity
BM is hypercellular with increased immature cells but less than 10% blasts
what is the chronic phase in chronic myelogenous leukemia (CML) or chronic granulocytic leukemia (CGL)?
responds well to therapy → normal health can be restored and maintained for months or years
what is the accelerated phase in chronic myelogenous leukemia (CML) or chronic granulocytic leukemia (CGL)?
about 30-40 months and is the typical disease course is transition to the accelerated stage
increased splenomegaly
rising leukocytosis
increased blasts
worsening anemia
thrombocytopenia
night sweats, weight loss, increased weakness, malaise, bone pain
30% of patients die before developing blastic crisis
what is the blastic crisis in chronic myelogenous leukemia (CML) or chronic granulocytic leukemia (CGL)?
usually develops after a short accelerated phase with some onsets are abrupt → CML transforms into AML or ALL… after onset of blast crisis, survival is about 1-2 months
what ages are more common for chronic lymphocytic leukemia (CLL) and what are the characteristics?
age is generally 60 years or older with males being more susceptible
often asymptomatic which the disease being discovered mostly on routine examination of PB (large numbers of mature looking lymphocytes)
enlarged lymph nodes, spleen, and liver are common
moderate anemia
what are the lab findings in chronic lymphocytic leukemia (CLL)?
WBCs are 50.0 - 200.0 × 10³/uL
platelets are usually in the low end of the normal range or slightly decreased
bone marrow shows increased numbers of lymphocytes (20-50%)
large numbers of mature-looking lymphocytes will accumulate
abnormally fragile so basket and smudge cells will be present when preparing a wedge smear
has abnormal function → most patients will demonstrate hypogammaglobulinemia
patient could survive many years without treatment
what are the characteristics in prolymphocytic leukemia?
cells will be between a blast and mature lymph and have a prominent single nucleolus
slight irregular clumping of chromatin with shape of nucleus oval to round
cytoplasm is easily seen and clear blue in color
what are the characteristics in hairy cell leukemia (type of chronic lymphocytic leukemia)?
has a higher incidence in males
identified by hair-like projections of cytoplasm
b cell origin and identified by presence of tartrate-resistant acid phosphatase positivity (TRAP)
massive splenomegaly
complaint of bone pain
extensive bone marrow involvement
present with pancytopenia → neutropenia and monocytopenia; patients have increased susceptibility to infection
what is sezary syndrome (type of chronic lymphocytic leukemia) and how is it characterized?
systemic form of mycosis fungoides (a T-cell cutaneous lymphoma)
sezary cells will be present → malignant lymphocytes (large mononuclear T-cells) and are very irregular, convoluted nuclear outline and finely distributed chromatin
the abnormal cell is a T-helper cell as identified by cell markers
what are the ways to distinguish leukemias?
cell type
clinical course
acute → short, if gone untreated, patient will die within 3-6 months
chronic → longer, months to years
what are the methods to classify leukemias?
cytochemistry
wright stain morphology
cytogenetics
cell markers
using monoclonal antibodies
DNA markers
necessary for treatment